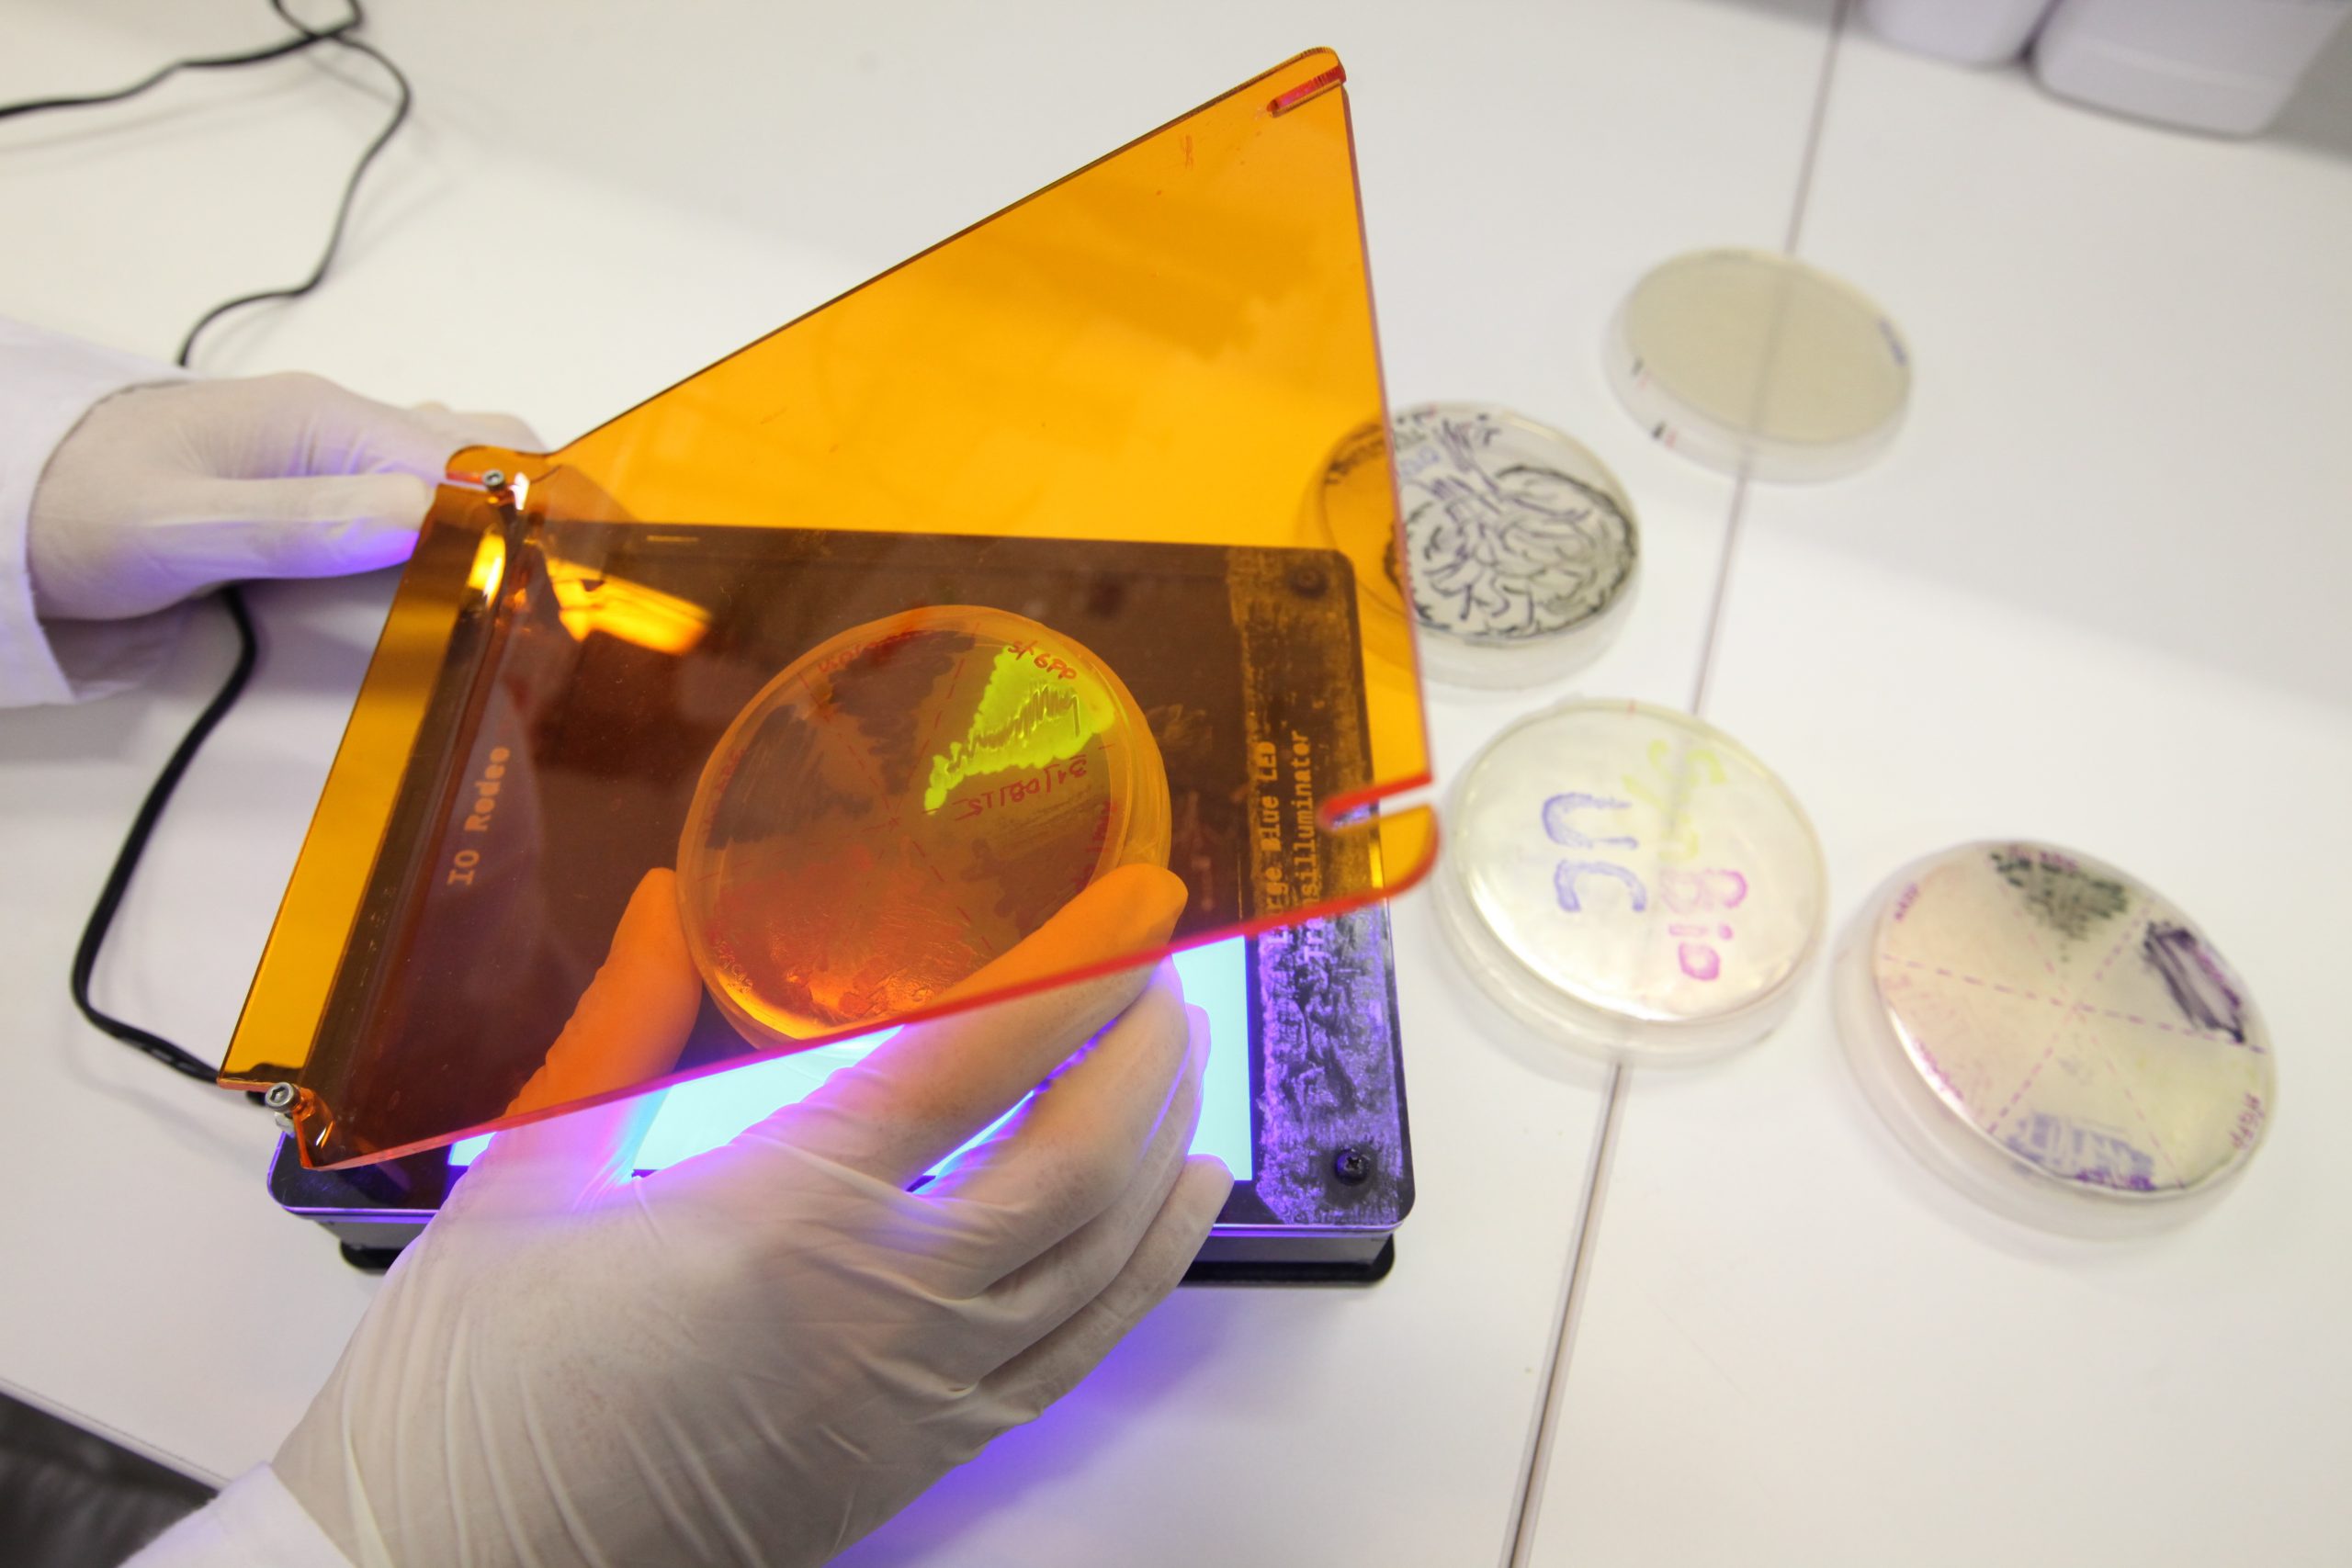

octubre 1, 2018
Facultad de Ciencias Biológicas participa en primera fase de Programa Ciencia 2030
En una iniciativa conjunta, cinco Facultades de nuestra Universidad se adjudicaron los primeros fondos del proyecto de Corfo Ciencia 2030, que busca fortalecer las capacidades de transferencia tecnológica, innovación y emprendimiento de base científica-tecnológica en las universidades chilenas. Se trata de las Facultades de Física, Química, Matemáticas, Agronomía -con su programa de doctorado- y la […]